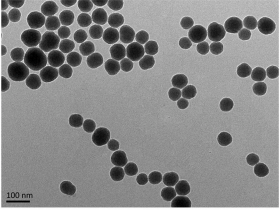

名稱:二氧化硅納米粒子(SiNPs)
組成:二氧化硅
粒徑:30-200nm
應用:生殖系統
儲存條件:-4℃
其他說明:密封狀態下保質期半年【主要優勢】以減少精子的數量和質量;SiNPs降低了魚精蛋白1(PRM1)的蛋白水平,提高了組蛋白的水平,并抑制了精子的染色質凝結。
題目:
Silica nanoparticles inhibiting the differentiation of round spermatid and chromatin remodeling of haploid period via MIWI in mice
章鏈接:https://www.x-mol.com/paper/1397308686999207936/t?adv
留言咨詢
|
|
 |
| 生物納米材料前沿 |
 |
| 納米醫學Frontier |
|
溫馨提示:蘇州北科納米供應產品僅用于科研,不能用于人體,不同批次產品規格性能有差異。網站部分文獻案例圖片源自互聯網,圖片僅供參考,請以實物為主,如有侵權請聯系我們立即刪除。
提示說明:納米材料工藝和制備可能會有改變 所有納米材料均支持按需定制 下單前聯系客服確認產品詳細信息。 |